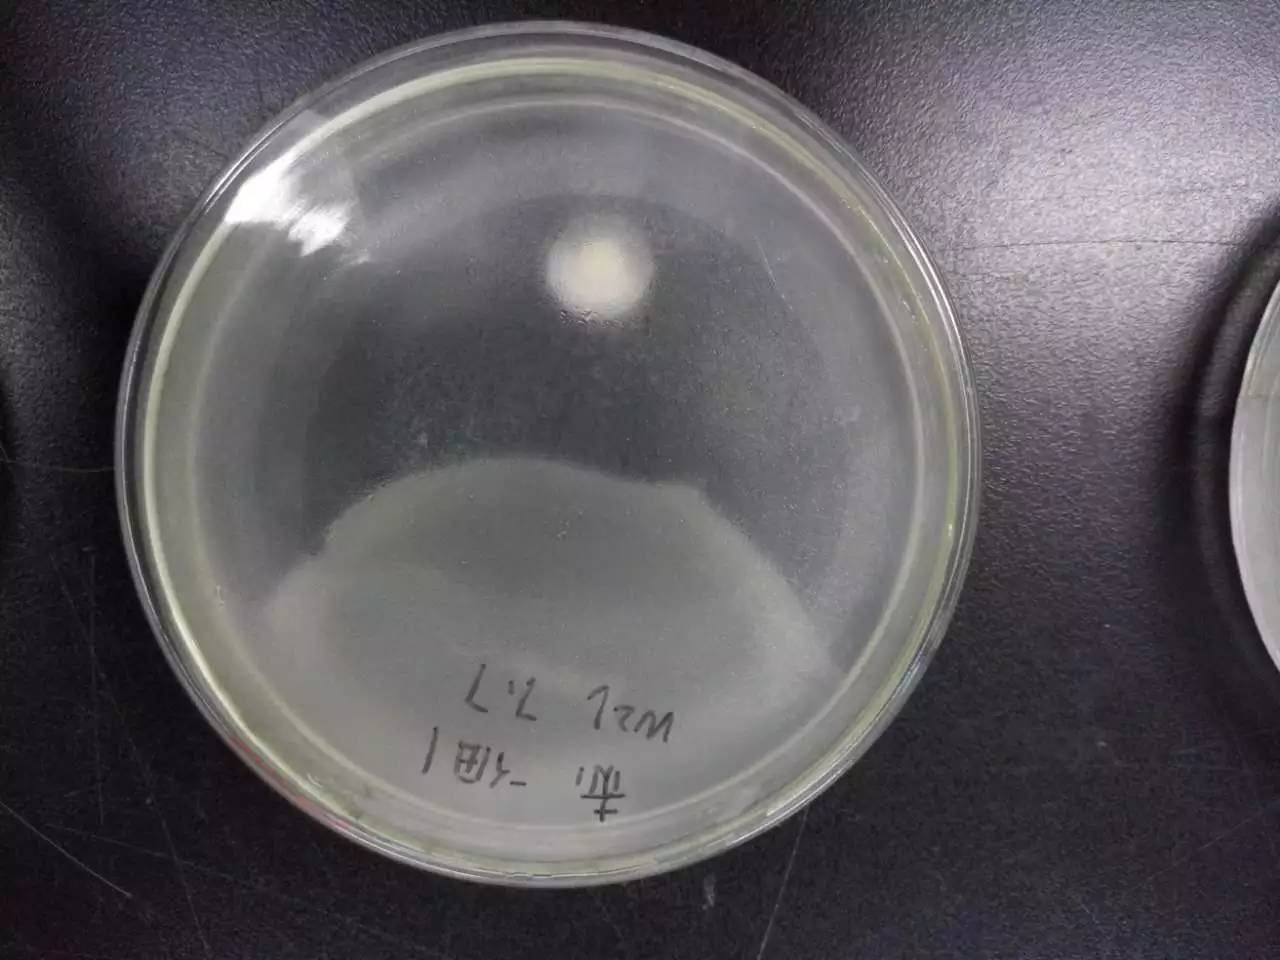

| 查看: 831 | 回复: 1 | |
[求助]
对峙实验为什么细菌长这样,我只划了一点点TT
|
|
|
|
|
萧寒哲木虫 (正式写手)
|
|
|
2楼2016-07-11 10:41:42
|
|

回复此楼